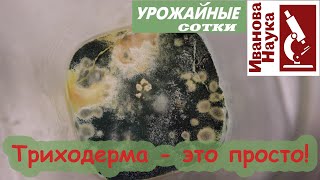

ЧТО ЕДЯТ ЗЕМЛЕРОЙКИ В ОГОРОДЕ
Землеройки – это насекомые, которые имеют большое значение в огороде, так как способствуют переработке почвы. Они питаются органическим материалом, разлагая его и внося в почву полезные элементы.
В их ежедневном рационе встречаются различные остатки растений, такие как опавшие листья, скончавшиеся цветы, плоды и корни растений. Они также питаются микроорганизмами, грибками и паразитами, которые находятся в почве.
Кроме того, землеройки также могут питаться мелкими грызунами и яйцами насекомых, которые представляют угрозу для сада и огорода. Их деятельность способствует повышению плодородия почвы и созданию условий для роста и развития растений.
Самый свирепый и прожорливый хищник, животные Евразии, землеройка
Он вылетел как пуля .Как быстро избавиться от крота на участке..
Что едят кроты в огороде и могут ли уничтожить урожай
Норы на садовом участке. Кто их роет и живёт в них? Решили проверить!
Как избавиться от Кротов раз и Навсегда.
КРОТЫ СБЕЖАЛИ КАК ОШПАРЕННЫЕ. Эффективный метод избавиться от кротов
Как быстро избавиться от кротов землероек и сусликов на огороде с помощью соли?
Земляная мышь - как избавиться.
Землеройки. Кто не спрятался, я не виноват.
Как бороться (избавиться) от кротов. Единственный эффективный метод.